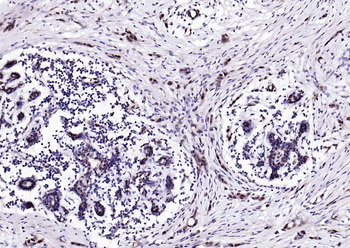
Estrogen receptor beta Rabbit Polyclonal Antibody
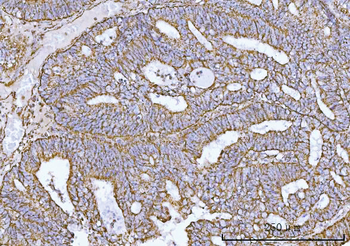
COX5B Antibody
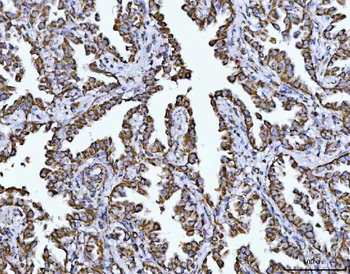
COX5B Antibody
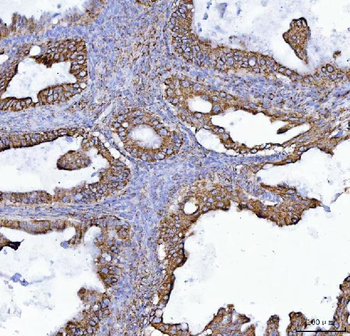
COX5B Antibody

You have no items in your shopping cart.
All Products
- Featured

ELISA, ICC, IF, IHC-Fr, IHC-P, WB
Human, Mouse, Rat
Mouse, Rat
Rabbit
Polyclonal
Unconjugated
100 μl, 50 μl, 200 μl - eNOS antibody [orb29800]Featured

ICC, IF, IHC-P, WB
Guinea pig, Human, Mouse, Porcine, Rat
Rabbit
Polyclonal
Unconjugated
100 μg - SCAMP3 Antibody [orb1939911]
ELISA, FC, ICC, IF, IHC, WB
Human, Rat
Rabbit
Polyclonal
Unconjugated
100 μg - ARS2/SRRT Antibody [orb1676512]
ELISA, FC, ICC, IF, IHC, IP, WB
Human, Mouse, Rat
Rabbit
Polyclonal
Unconjugated
100 μg - Cytokeratin 20/Krt20 Antibody [orb614125]
ELISA, FC, ICC, IF, IHC, WB
Human, Mouse, Rat
Rabbit
Polyclonal
Unconjugated
100 μg - UBE2I UBC9 Antibody [orb443231]
FC, ICC, IF, IHC, IHC-Fr, WB
Human, Mouse, Rat
Rabbit
Polyclonal
Unconjugated
100 μg - SEC23IP Antibody [orb1402107]
ELISA, FC, ICC, IF, IHC, WB
Human, Monkey, Mouse, Rat
Rabbit
Polyclonal
Unconjugated
100 μg - COX5B Antibody [orb1173497]
ELISA, FC, ICC, IF, IHC, WB
Human, Mouse, Rat
Rabbit
Polyclonal
Unconjugated
100 μg